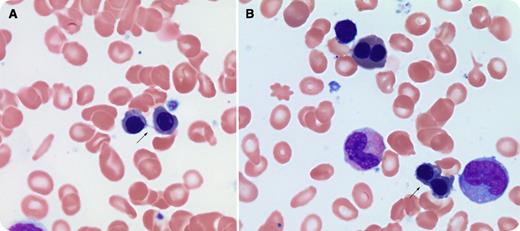
A 68-year-old woman with rheumatoid arthritis controlled with methotrexate, meloxicam, and prednisone was found to have chronic anemia and thrombocytopenia. Her complete blood count panel showed a white blood cell level of 4.8 × 109/L, neutrophils 2.2 × 109/L, hemoglobin 106 g/L, mean corpuscular volume 95.5 fL, and platelet count 45 × 109/L. Her bone marrow analysis revealed dysplastic features in all lineages with <3% blasts. The erythroid precursors in particular showed binucleate forms, some with chromatin bridging (panels A-B) and nuclear budding. These findings are in keeping with an underlying diagnosis of myelodysplastic syndrome (MDS). / Internuclear chromatin bridging is a fine or coarse band of nuclear material connecting 2 nuclei. It is a relatively uncommon morphologic finding not associated with normal marrow and is a sign of impaired mitosis that results from failure of sister chromatids to separate during cell division. This phenomenon can be seen in all subtypes of MDS. Although chromatin bridging is characteristic of the rare condition congenital dyserythropoietic anemia type 1 in an elderly patient, it may suggest MDS. Further, internuclear chromatin bridging may contribute to the addition and deletion of genetic material, which is often a feature of MDS.

A 68-year-old woman with rheumatoid arthritis controlled with methotrexate, meloxicam, and prednisone was found to have chronic anemia and thrombocytopenia. Her complete blood count panel showed a white blood cell level of 4.8 × 109/L, neutrophils 2.2 × 109/L, hemoglobin 106 g/L, mean corpuscular volume 95.5 fL, and platelet count 45 × 109/L. Her bone marrow analysis revealed dysplastic features in all lineages with <3% blasts. The erythroid precursors in particular showed binucleate forms, some with chromatin bridging (panels A-B) and nuclear budding. These findings are in keeping with an underlying diagnosis of myelodysplastic syndrome (MDS).
Internuclear chromatin bridging is a fine or coarse band of nuclear material connecting 2 nuclei. It is a relatively uncommon morphologic finding not associated with normal marrow and is a sign of impaired mitosis that results from failure of sister chromatids to separate during cell division. This phenomenon can be seen in all subtypes of MDS. Although chromatin bridging is characteristic of the rare condition congenital dyserythropoietic anemia type 1 in an elderly patient, it may suggest MDS. Further, internuclear chromatin bridging may contribute to the addition and deletion of genetic material, which is often a feature of MDS.
A 68-year-old woman with rheumatoid arthritis controlled with methotrexate, meloxicam, and prednisone was found to have chronic anemia and thrombocytopenia. Her complete blood count panel showed a white blood cell level of 4.8 × 109/L, neutrophils 2.2 × 109/L, hemoglobin 106 g/L, mean corpuscular volume 95.5 fL, and platelet count 45 × 109/L. Her bone marrow analysis revealed dysplastic features in all lineages with <3% blasts. The erythroid precursors in particular showed binucleate forms, some with chromatin bridging (panels A-B) and nuclear budding. These findings are in keeping with an underlying diagnosis of myelodysplastic syndrome (MDS).
Internuclear chromatin bridging is a fine or coarse band of nuclear material connecting 2 nuclei. It is a relatively uncommon morphologic finding not associated with normal marrow and is a sign of impaired mitosis that results from failure of sister chromatids to separate during cell division. This phenomenon can be seen in all subtypes of MDS. Although chromatin bridging is characteristic of the rare condition congenital dyserythropoietic anemia type 1 in an elderly patient, it may suggest MDS. Further, internuclear chromatin bridging may contribute to the addition and deletion of genetic material, which is often a feature of MDS.
For additional images, visit the ASH IMAGE BANK, a reference and teaching tool that is continually updated with new atlas and case study images. For more information visit http://imagebank.hematology.org.